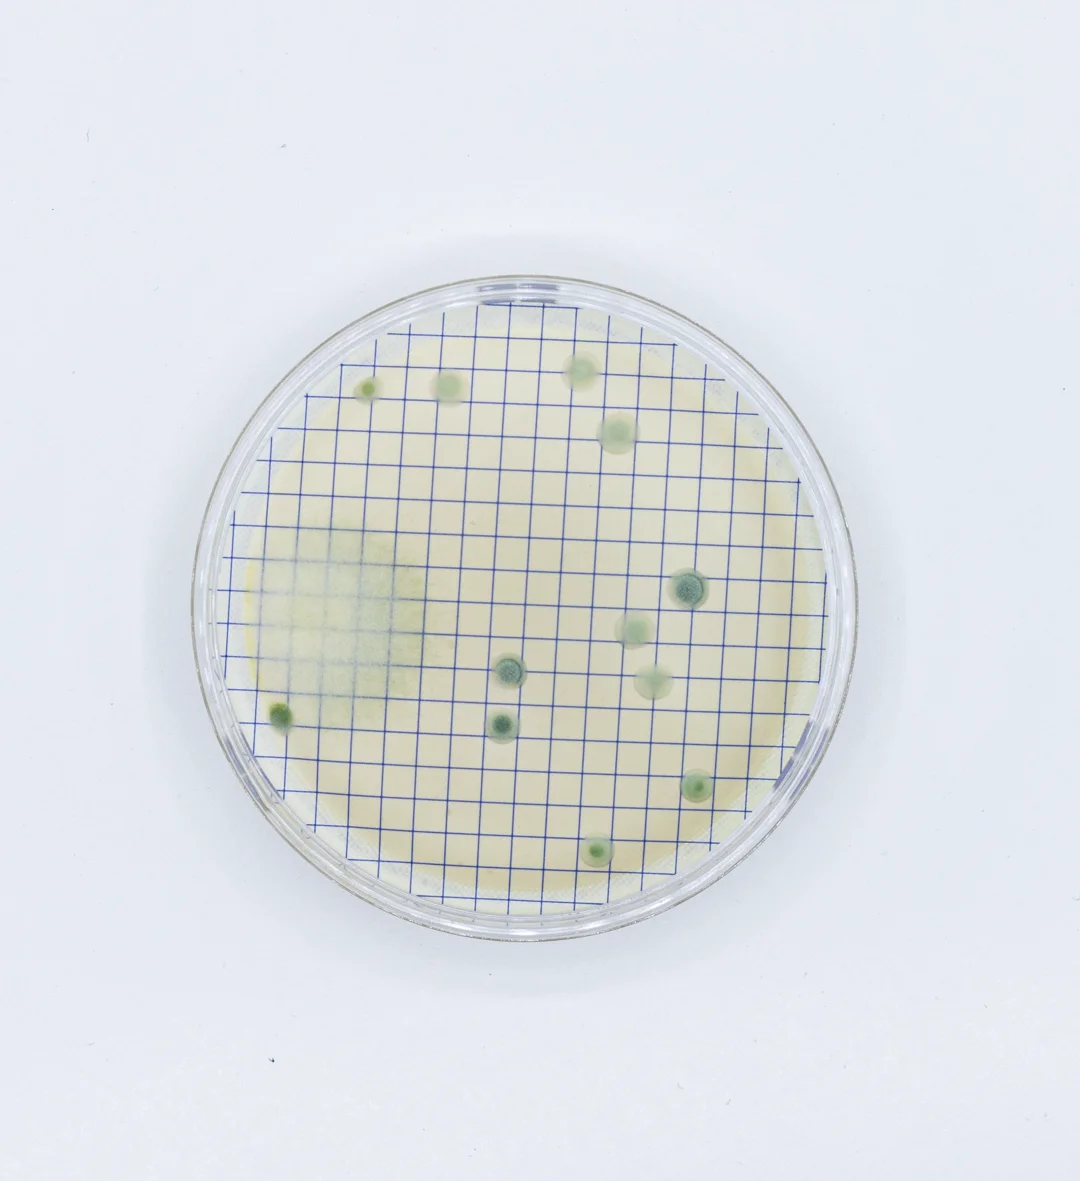
M-Green ampoule for fungi and yeast detection

Caldo M-GreenMushrooms and yeasts
Means used for routine tests in water and beverage sample analysis.
Means used for routine tests in water and beverage sample analysis, M-Green Mushrooms and ampoule yeasts, is a prepared medium, ready for use in membrane filtration analysis for the detection of fungi and yeasts in beverages and waters.
Principle of procedure
Casein and gelatin peptone provide nitrogen, vitamins, minerals, and amino acids essential for the growth of fungi and yeasts. Yeast extract is a source of vitamins, particularly from group B. Dextrose is the fermentable carbohydrate that provides carbon and energy. Potassium phosphate regulates pH. Magnesium sulphate, thiamine, and diastase (a mixture containing amylolytic enzymes that degrade starch) provide essential ions, minerals, and nutrients.
Bromocresol green is a pH indicator, which pigments the mycotic colonies of green facilitating their visualization and count. The yeasts form opaque colonies of green color and the mold appears green and filamentous. The metabolic by-products of the mycotic development spread in the surrounding environment reducing the pH, which inhibits bacterial proliferation. The acid reaction produced converts the residual indicator into yellow.